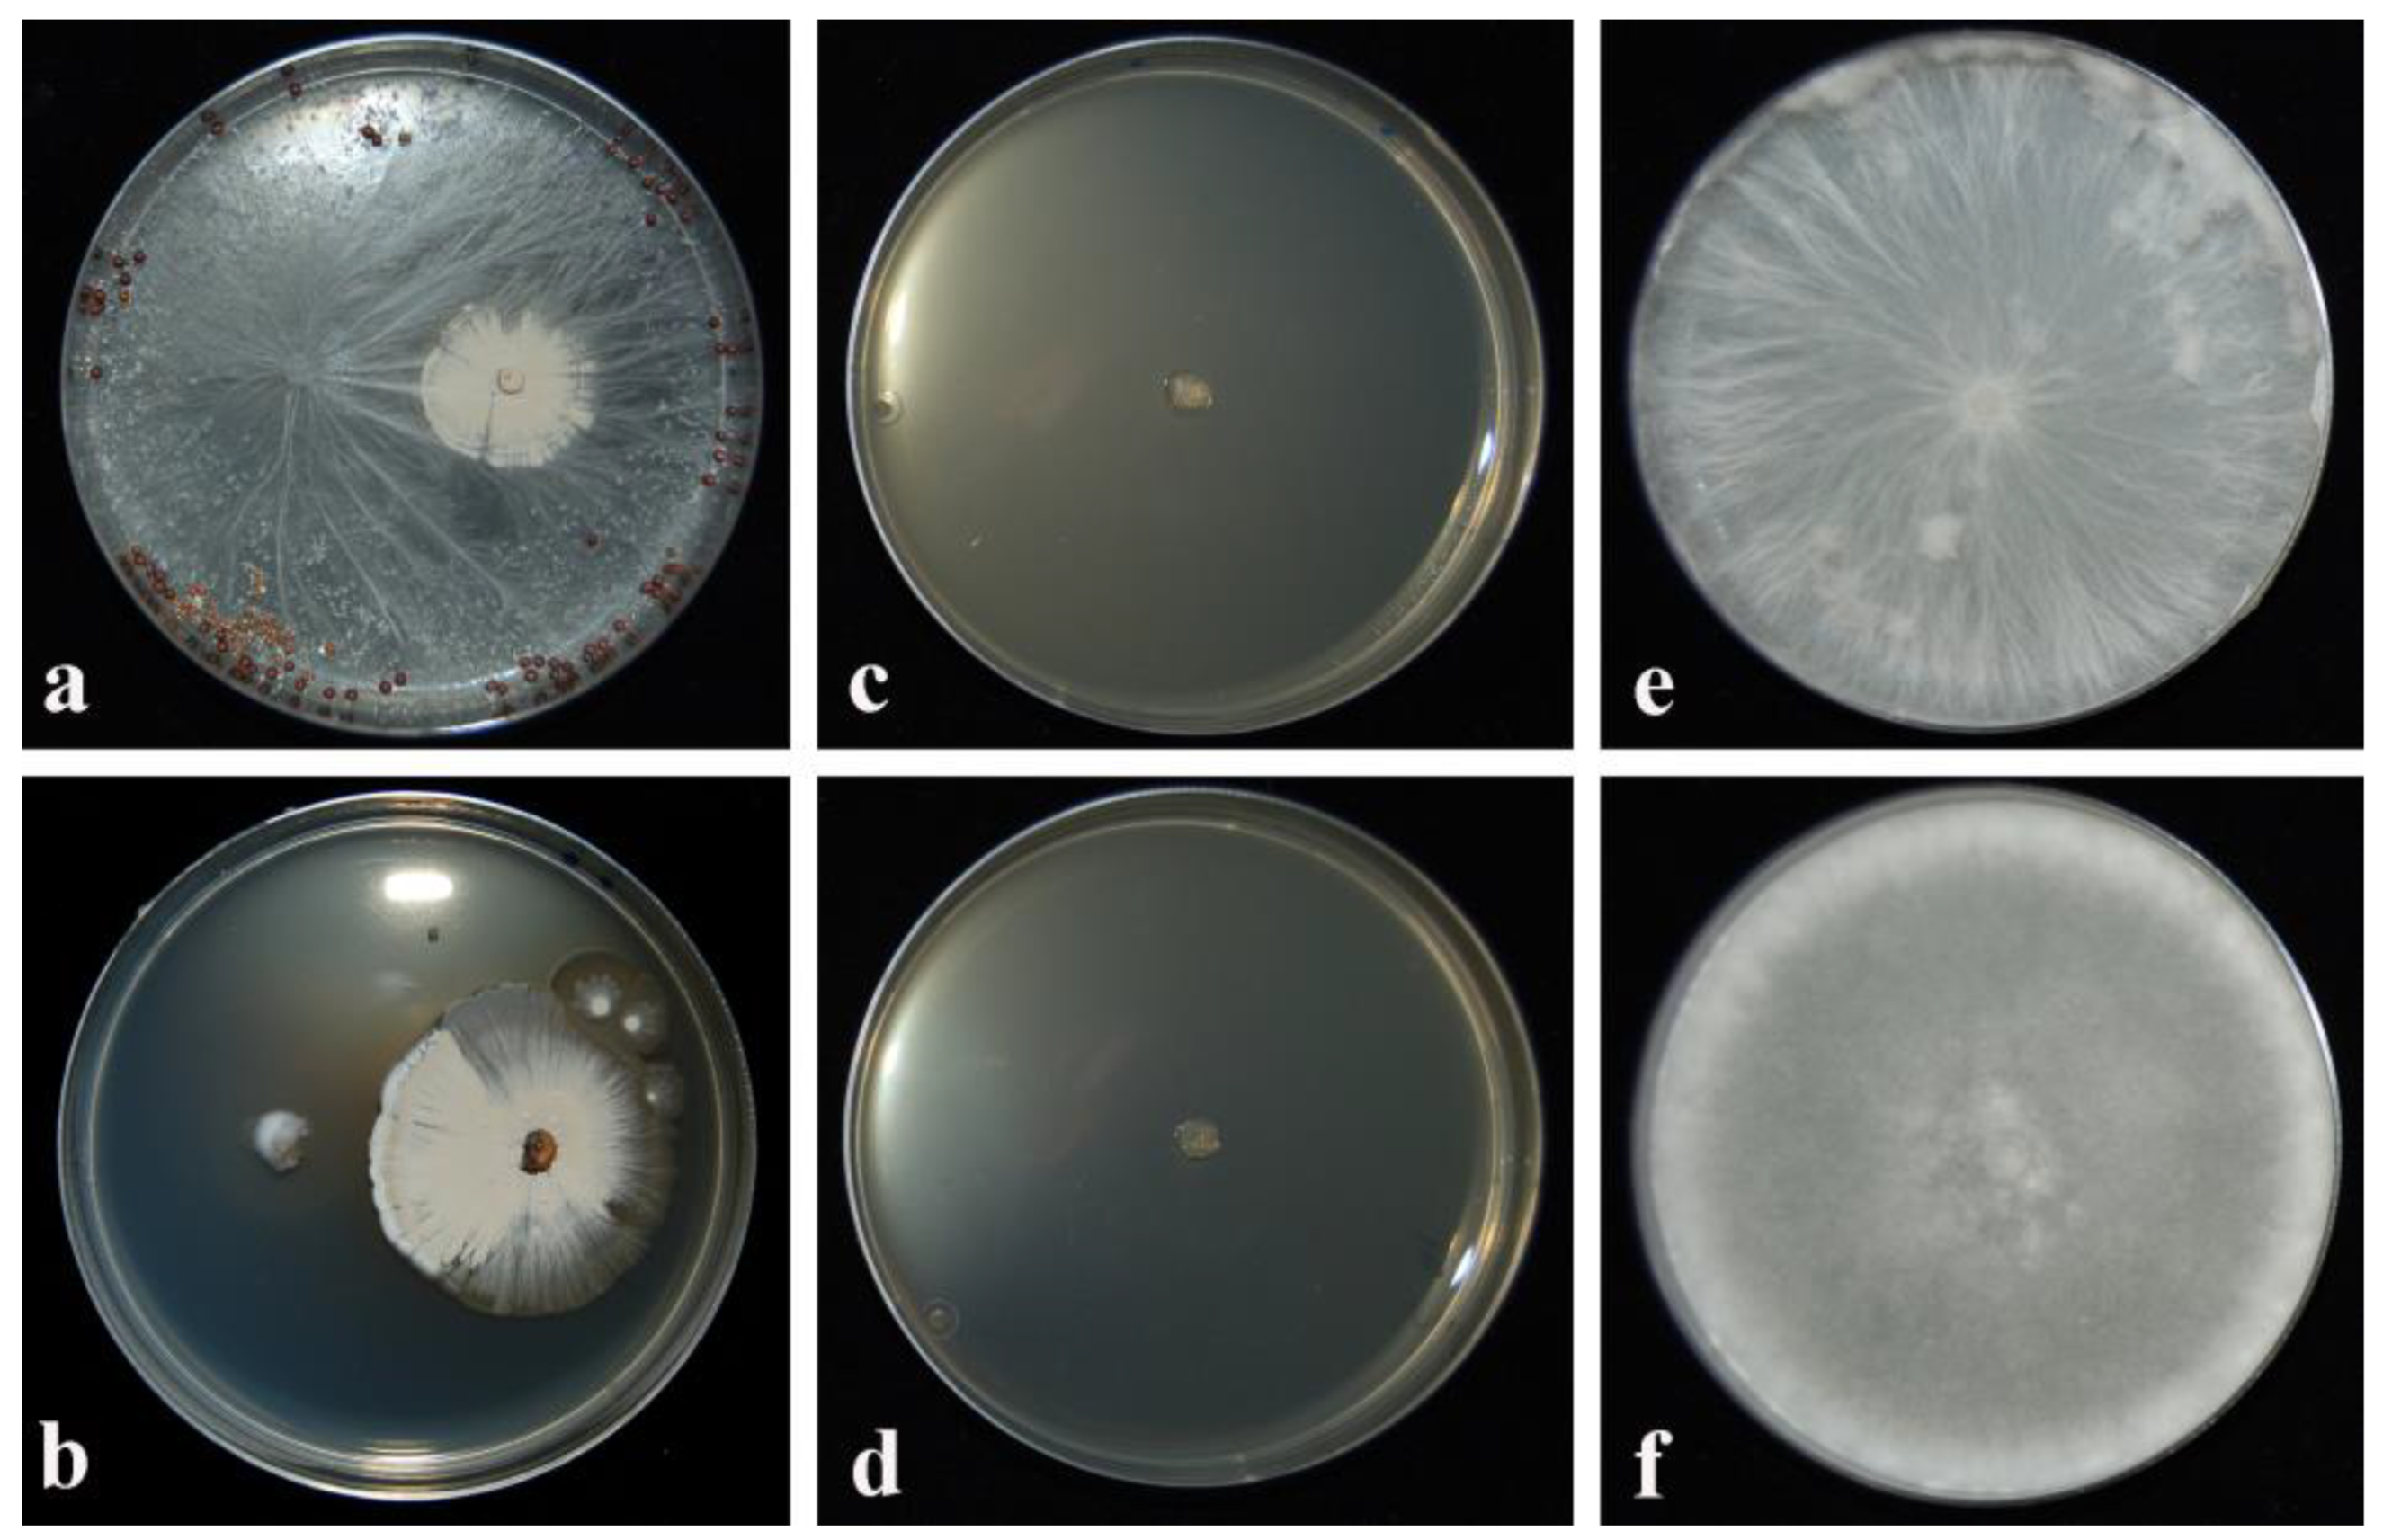
Plants 12 02025 g001 Plants 12 02025 g001

Biological Control of Severe Fungal Phytopathogens by Streptomyces albidoflavus Strain CARA17 and Its Bioactive Crude Extracts on Lettuce Plants
Abstract
1. Introduction
2. Results
2.1. Assessment of Inhibitory Activity (IA) by CARA17 Strain in Dual Culture and As Culture Filtrate Added to Culture Medium
2.2. Assessment of Antagonistic Effectiveness of CARA17 Strain on Lactuca sativa L. Seedlings against Fungal Soilborne Pathogens In Vivo
3. Discussion
4. Materials and Methods
4.1. Actinomycetes Strain and Soilborne Phytopathogens
4.2. Assessment of Inhibitory Activity by CARA17 Strain in Dual Culture and As Culture Filtrate
4.3. Assessment of Antagonistic Effectiveness of CARA17 Strain on Lactuca sativa L. Seedlings against Fungal Soilborne Pathogens In Vivo
Author Contributions
Funding
Conflicts of Interest
References
- ISTAT (Istituto Nazionale di Statistica). Ortive. 2022. Available online: http://dati.istat (accessed on 30 March 2022).
- Nordskog, B.; Nærstad, R.; Herrero, M.L.; Sundheim, L.; Hermansen, A. Fungal pathogens in Norwegian lettuce fields. Acta Agric. Scand. B Soil Plant Sci. 2008, 58, 230–235. [Google Scholar] [CrossRef]
- Gilardi, G.; Matic, S.; Gullino, M.L.; Garibaldi, A. First report of root rot caused by Pythium sylvaticum on lettuce in Italy. Plant Dis. 2018, 102, 454. [Google Scholar] [CrossRef]
- Koike, S.T.; Stanghellini, H.; Burkhardt, A. First report of Phytophthora root rot caused by Phytophthora cryptogea on field-grown lettuce in California. Plant Dis. 2021, 105, 2257. [Google Scholar] [CrossRef]
- Shrestha, U.; Swilling, K.J.; Butler, D.M.; Ownley, B.H. First report of basal drop and white mold on lettuce, broccoli, and mustard caused by Sclerotinia sclerotiorum in Tennessee, U.S.A. Plant Dis. 2018, 102, 249. [Google Scholar] [CrossRef]
- Supakitthanakorn, S.; Ruangwong, O.U.; Sawangrat, C.; Srisuwan, W.; Boonyawan, D. Potential of nonthermal atmospheric-pressure dielectric barrier discharge plasma for inhibition of Athelia rolfsii causing southern blight disease in lettuce. Agriculture 2023, 13, 167. [Google Scholar] [CrossRef]
- Mamo, B.E.; Eriksen, R.L.; Adhikari, N.D.; Hayes, R.J.; Mou, B.; Simko, I. Epidemiological characterization of lettuce drop (Sclerotinia spp.) and biophysical features of the host identify soft stem as a susceptibility factor. PhytoFrontiers 2021, 1, 182–204. [Google Scholar] [CrossRef]
- Gilardi, G.; Garibaldi, A.; Matic, S.; Senatore, M.T.; Pipponzi, S.; Prodi, A.; Gullino, M.L. First report of Fusarium oxysporum f. sp. lactucae race 4 on lettuce in Italy. Plant Dis. 2019, 103, 2680. [Google Scholar]
- O’Sullivan, C.A.; Belt, K.; Thatcher, L.F. Tackling Control of a Cosmopolitan Phytopathogen: Sclerotinia. Front. Plant Sci. 2021, 12, 707509. [Google Scholar] [CrossRef]
- Smolińska, U.; Kowalska, B. Biological control of the soil-borne fungal pathogen Sclerotinia sclerotiorum—A review. J. Plant Path. 2018, 100, 1–12. [Google Scholar] [CrossRef]
- Bellini, A.; Gilardi, G.; Idbella, M.; Zotti, M.; Pugliese, M.; Bonanomi, G.; Gullino, M.L.; Gullino, M. Trichoderma enriched compost, BCAs and potassium phosphite control Fusarium wilt of lettuce without affecting soil microbiome at genus level. Appl. Soil Ecol. 2023, 182, 104678. [Google Scholar] [CrossRef]
- Kowalska, B.; Smolińska, U.; Szczech, M.; Winciorek, J. Application of organic waste material overgrown with Trichoderma atroviride as a control strategy for Sclerotinia sclerotiorum and Chalara thielavioides in soil. J. Plant Prot. Res. 2017, 57, 205–211. [Google Scholar] [CrossRef]
- Oktay, E.; Kemal, B. Biological control of Verticillium wilt on cotton by the use of fluorescent Pseudomonas spp. under field conditions. Biol. Control 2010, 53, 39–45. [Google Scholar]
- Khan, M.; Salman, M.; Jan, S.A.; Shinwari, Z.K. Biological control of fungal phytopathogens: A comprehensive review based on Bacillus species. MOJ Biol. Med. 2021, 6, 90–92. [Google Scholar] [CrossRef]
- Carlucci, A.; Raimondo, M.L.; Colucci, D.; Lops, F. Streptomyces albidoflavus strain CARA17 as biocontrol agent against fungal soil-borne pathogens on fennel plants. Plants 2022, 11, 1420. [Google Scholar] [CrossRef] [PubMed]
- Xue, L.; Xue, Q.; Chen, Q.; Lin, C.; Shen, G.; Zhao, J. Isolation and evaluation of rhizosphere actinomycetes with potential application for biocontrol of Verticillium wilt of cotton. Crop Prot. 2013, 43, 231–240. [Google Scholar] [CrossRef]
- Zeng, Q.; Huang, H.; Zhu, J.; Fang, Z.; Sun, Q.; Bao, S. A new nematicidal compound produced by Streptomyces albogriseolus HA10002. Antonie Van Leeuwenhoek 2013, 103, 1107–1111. [Google Scholar] [CrossRef]
- Kämpfer, P. The family Streptomycetaceae, part I: Taxonomy. In The Prokaryotes; Dworkin, M., Ed.; Springer: Berlin/Heidelberg, Germany, 2006; pp. 538–604. [Google Scholar]
- Demain, A.L. Antibiotics: Natural products essential to human health. Med. Res. Rev. 2009, 29, 821–842. [Google Scholar] [CrossRef] [PubMed]
- Bhavana, M.; Talluri, V.P.; Kumar, K.S.; Rajagopal, S. Optimization of culture conditions of Streptomyces carpaticus (MTCC-11062) for the production of antimicrobial compound. Int. J. Pharm. Pharm. Sci. 2014, 6, 281–285. [Google Scholar]
- Kurnianto, M.A.; Kusumaningrum, H.D.; Lioe, H.N. Characterization of Streptomyces isolates associated with estuarine fish Chanos chanos and profiling of their antibacterial metabolites-crude-extract. Int. J. Microbiol. 2020, 23, 8851947. [Google Scholar] [CrossRef]
- Kaur, T.; Rani, R.; Manhas, R.K. Biocontrol and plant growth promoting potential of phylogenetically new Streptomyces sp. MR14 of rhizospheric origin. AMB Express 2019, 9, 125. [Google Scholar] [CrossRef]
- De Curtis, F.; Lima, G.; Vitullo, D.; De Cicco, V. Biocontrol of Rhizoctonia solani and Sclerotium rolfsii on tomato by delivering antagonistic bacteria through a drip irrigation system. Crop Prot. 2010, 29, 663–670. [Google Scholar] [CrossRef]
- Karthikeyan, V.; Gnanamanickam, S.S. Biological control of Setaria blast (Magnaporthe grisea) with bacteria strains. Crop Prot. 2008, 27, 263–267. [Google Scholar] [CrossRef]
- Kim, H.J.; Lee, S.C.; Hwang, B.K. Streptomyces cheonanensis sp. nov., a novel streptomycete with antifungal activity. Int. J. Syst. Evol. Microbiol. 2006, 56, 471–475. [Google Scholar] [CrossRef]
- Bressan, W.; Figueiredo, J.E.F. Efficacy and dose-response relationship in biocontrol of Fusarium disease in maize by Streptomyces spp. Eur. J. Plant Pathol. 2008, 120, 311–316. [Google Scholar] [CrossRef]
- Ouhdouch, Y.; Barakate, M.; Finanse, C. Actinomycetes of Moroccan habitats: Isolation and screening for antifungal activities. Eur. J. Soil Biol. 2001, 37, 69–74. [Google Scholar] [CrossRef]
- Faheem, M.; Raza, W.; Zhong, W.; Nan, Z.; Shen, Q.; Xu, Y. Evaluation of the biocontrol potential of Streptomyces goshikiensis YCXU against Fusarium oxysporum f. sp. niveum. Biol. Control 2015, 81, 101–110. [Google Scholar] [CrossRef]
- Newitt, J.T.; Prudence, S.M.M.; Hutchings, M.I.; Worsley, S.F. Biocontrol of cereal crop diseases using Streptomycetes. Pathogens 2019, 8, 78. [Google Scholar] [CrossRef]
- Law, J.W.-F.; Ser, H.-L.; Khan, T.M.; Chuah, L.-H.; Pusparajah, P.; Chan, K.-G.; Goh, B.-H.; Lee, L.-H. The Potential of Streptomyces as Biocontrol Agents against the Rice Blast Fungus, Magnaporthe oryzae (Pyricularia oryzae). Front. Microbiol. 2017, 8, 3. [Google Scholar] [CrossRef] [PubMed]
- Colombo, E.M.; Kunova, A.; Pizzatti, C.; Saracchi, M.; Cortesi, P.; Pasquali, M. Selection of an endophytic Streptomyces sp. strain DEF09 from wheat roots as a biocontrol agent against Fusarium graminearum. Front. Microbiol. 2019, 10, 2356. [Google Scholar] [CrossRef]
- Passari, A.K.; Mishra, V.K.; Gupta, V.K.; Yadav, M.K.; Saikia, R.; Singh, B.P. In vitro and in vivo plant-growth-promoting activities and DNA fingerprinting of antagonistic endophytic actinomycetes associates with medicinal plants. PLoS ONE 2015, 10, 139468. [Google Scholar] [CrossRef] [PubMed]
- De-Oliveira, M.F.; Da Silva, M.G.; Van Der Sand, S.T. Anti-phytopathogen potential of endophytic actinobacteria isolated from tomato plants (Lycopersicon esculentum) in southern Brazil, and characterization of Streptomyces sp. R18, a potential biocontrol agent. Res. Microbiol. 2010, 161, 565–572. [Google Scholar] [CrossRef] [PubMed]
- Zeng, W.; Wang, D.; Kirk, W.; Hao, J. Use of Coniothyrium minitans and other microorganisms for reducing Sclerotinia sclerotiorum. Biol. Control 2012, 60, 225–232. [Google Scholar] [CrossRef]
- Aleandri, M.P.; Chilosi, G.; Bruni, N.; Tomassini, A.; Vettraino, A.M.; Vannini, A. Use of nursery potting mixes amended with local Trichoderma strains with multiple complementary mechanisms to control soil-borne disease. Crop Prot. 2015, 67, 269–278. [Google Scholar] [CrossRef]
- Chilosi, G.; Aleandri, M.A.; Luccioli, E.; Stazi, S.R.; Marabottini, R.; Morales-Rodríguez, C.; Vettraino, A.N.; Vannini, A. Suppression of soil-borne plant pathogens in growing media amended with espresso spent coffee grounds as a carrier of Trichoderma spp. Sci. Hortic. 2020, 259, 108666. [Google Scholar] [CrossRef]
- Savchuk, S.; Fernando, W.G.D. Effect of timing of application and population dynamics on the degree of biological control of Sclerotinia sclerotiorum by bacterial antagonists. FEMS Microbiol. Ecol. 2004, 49, 376–388. [Google Scholar] [CrossRef]
- Fernando, W.G.D.; Nakkeeran, S.; Zhang, Y.; Savchuk, S. Biological control of Sclerotinia sclerotiorum (Lib.) de Bary by Pseudomonas and Bacillus species on canola petals. Crop Prot. 2007, 26, 100–107. [Google Scholar] [CrossRef]
| CARA17 Strain—Culture Filtrate | ||||
|---|---|---|---|---|
| Soilborne Fungus | Thermally Pretreated | Quantity Added to Culture Medium (%) (v/v) | Inhibitory Activity (%) | |
| Mean | SD | |||
| Athelia rolfsii | 121 °C | 15 | 22.81 A * | 4.94 |
| Sclerotinia sclerotiorum | 121 °C | 15 | 50.50 B | 13.50 |
| Sclerotinia sclerotiorum | 121 °C | 30 | 85.68 C | 1.18 |
| Sclerotinia sclerotiorum | 121 °C | 50 | 85.94 C | 0.28 |
| Athelia rolfsii | 100 °C | 15 | 88.99 C | 1.24 |
| Athelia rolfsii | 121 °C | 30 | 89.56 C | 1.81 |
| Athelia rolfsii | 121 °C | 50 | 90.59 CD | 1.15 |
| Sclerotinia sclerotiorum | 100 °C | 15 | 91.09 CD | 5.63 |
| Athelia rolfsii | 100 °C | 30 | 93.05 CDE | 6.19 |
| Sclerotinia sclerotiorum | 100 °C | 30 | 96.92 DE | 0.44 |
| Sclerotinia sclerotiorum | 100 °C | 50 | 100.00 E | 0.00 |
| Athelia rolfsii | 100 °C | 50 | 100.00 E | 0.00 |
| Inhibitory Activity (IA) % | ||||
|---|---|---|---|---|
| Fungal Soilborne Isolates | Dual Culture after 21 Days | GYMA Amended with 50% of CARA17 Culture Filtrate after 6 Days | ||
| Mean | Min–Max b | Mean | Min–Max | |
| Athelia rolfsii | 0.00 B a | 0.00–0.00 | 100.00 A | 100.00–100.00 |
| Sclerotinia sclerotiorum | 100.00 A | 100.00–100.00 | 100.00 A | 100.00–100.00 |
| Treatment with CARA17 Strain by Dipping for 12 h | Fungal Pathogen | Phytosanitary Status of Lettuce Seedlings | Disease Severity and Symptom Description | Pathogen Re-Isolation from Root n(/%) * | |||||
|---|---|---|---|---|---|---|---|---|---|
| Healthy Seedlings (n/%) | Symptomatic Seedlings (n/%) | DS | Root | DS | Leaves | Healthy Seedlings | Symptomatic Seedlings | ||
| Filtrate inoculum a | A. rolfsii | 48 (80.0) | 12 (20.0) | 1.6 | Root rot | 1.0 | Marginal necrosis | 2 (4.2) | 10 (84) |
| Filtrate inoculum a | S. sclerotiorum | 52 (86.7) | 6 (13.3) | 0.6 | Root rot | 0.4 | Marginal browning and light necrosis | 1 (1.9) | 6 (100) |
| Propagule inoculum | A. rolfsii | 53 (88.3) | 7 (11.7) | 1.2 | Root rot | 0.6 | Marginal necrosis | 4 (7.5) | 7 (100) |
| Propagule inoculum | S. sclerotiorum | 59 (98.3) | 1 (1.7) | 0.6 | Root rot | 0.4 | Marginal browning and light necrosis | 6 (10.2) | 1 (100) |
| No treatment b | A. rolfsii | 0 (0.0) | 60 (100.0) | 5.0 | Root rot | 5.0 | Damping off | 0 (0.0) | 58 (97) |
| No treatment b | S. sclerotiorum | 0 (0.0) | 60 (100.0) | 3.9 | Root rot | 4.5 | Damping off | 0 (0.0) | 60 (100) |
| Filtrate inoculum | - | 60 (100.0) | 0 (0.0) | 0.0 | No disease symptoms | 0.0 | No disease symptoms | - | - |
| Propagule inoculum | - | 60 (100.0) | 0 (0.0) | 0.0 | No disease symptoms | 0.0 | No disease symptoms | - | - |
| Control, tap water c | - | 60 (100.0) | 0 (0.09 | 0.0 | No disease symptoms | 0.0 | No disease symptoms | - | - |
Disclaimer/Publisher’s Note: The statements, opinions and data contained in all publications are solely those of the individual author(s) and contributor(s) and not of MDPI and/or the editor(s). MDPI and/or the editor(s) disclaim responsibility for any injury to people or property resulting from any ideas, methods, instructions or products referred to in the content. |
© 2023 by the authors. Licensee MDPI, Basel, Switzerland. This article is an open access article distributed under the terms and conditions of the Creative Commons Attribution (CC BY) license (https://creativecommons.org/licenses/by/4.0/).
Share and Cite
Carlucci, A.; Sorbo, A.; Colucci, D.; Raimondo, M.L. Biological Control of Severe Fungal Phytopathogens by Streptomyces albidoflavus Strain CARA17 and Its Bioactive Crude Extracts on Lettuce Plants. Plants 2023, 12, 2025. https://doi.org/10.3390/plants12102025
Carlucci A, Sorbo A, Colucci D, Raimondo ML. Biological Control of Severe Fungal Phytopathogens by Streptomyces albidoflavus Strain CARA17 and Its Bioactive Crude Extracts on Lettuce Plants. Plants. 2023; 12(10):2025. https://doi.org/10.3390/plants12102025
Chicago/Turabian StyleCarlucci, Antonia, Andrea Sorbo, Donato Colucci, and Maria Luisa Raimondo. 2023. "Biological Control of Severe Fungal Phytopathogens by Streptomyces albidoflavus Strain CARA17 and Its Bioactive Crude Extracts on Lettuce Plants" Plants 12, no. 10: 2025. https://doi.org/10.3390/plants12102025
APA StyleCarlucci, A., Sorbo, A., Colucci, D., & Raimondo, M. L. (2023). Biological Control of Severe Fungal Phytopathogens by Streptomyces albidoflavus Strain CARA17 and Its Bioactive Crude Extracts on Lettuce Plants. Plants, 12(10), 2025. https://doi.org/10.3390/plants12102025

